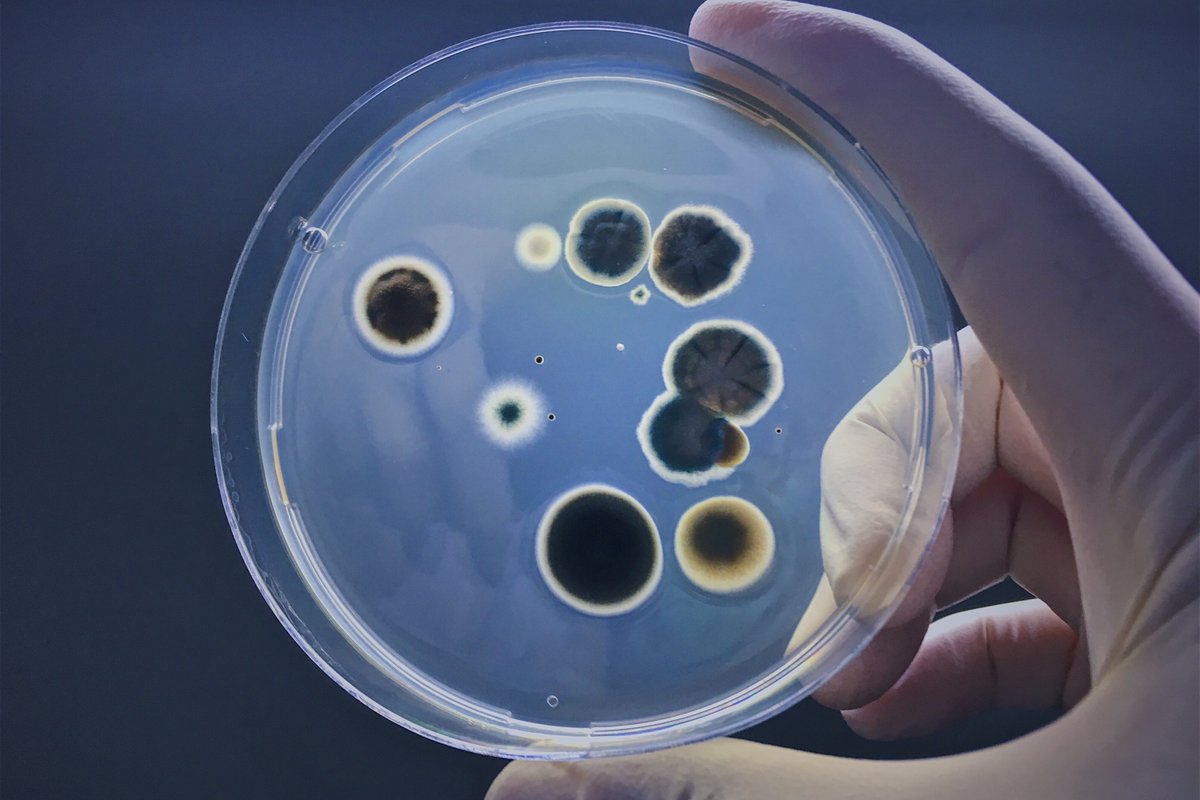
Ben Smith tweet media

Ben Smith
8.8K posts

Ben Smith
@bensmithlive
Built a reputation reversing chronic health issues • Worked with 1,353 clients to heal their gut • Creating guided health recovery systems with AI



You can spend $30,000 on home remediation and still test positive for mold mycotoxins 8 months later. Most people detox while still living in the poison. But even if you remove the source, the mycotoxins don't leave when you do. They bind to fat tissue and stay there for months (sometimes years) poisoning you from the inside. Think of mycotoxins like microscopic velcro stuck to your cell membranes. Your liver tries to process them like normal toxins, but they won't budge from fatty tissues in your brain, liver, and nervous system. Conventional detox protocols fail because they're trying to wash off velcro with water. Dr. Shoemaker's research discovered 24% of people have a genetic variation (HLA-DR) that makes them unable to clear biotoxins naturally. These people store mycotoxins indefinitely unless action is taken. Most doctors have never heard of this gene. Symptoms like brain fog, chronic fatigue, anxiety, insomnia—these are mycotoxins interfering with mitochondrial function in real time. The ones who recover aren't the ones with the cleanest new homes. They were the ones who understand this isn't about their environment anymore. It's about their fat tissue. Because their body has become the moldy building itself. Here's a phased approach I found to work for our clients ↓ Step 1: Mobilise the toxins from fat storage • Liposomal glutathione, 500mg (cellular protection) • Phosphatidylcholine, 900–1200mg (stimulate bile flow) • Sauna 4x/week (heat mobilises fat-stored toxins) • Niacin, 50mg (optional pre-sauna) Step 2: Bind the mycotoxins (take 2 hours away from food/supplements) • Colestyramine, 4g 1-2x/day (bile-acid binder for certain mycotoxins) • GI Detox+, 1-2 caps (broad binder) • Chlorella 3g (gentle binder) • Calcium-D-Glucarate, 500-1000mg (reduce toxin circulation) Step 3: Facilitate elimination pathways • 3L+ filtered water daily (with balanced electrolytes) • Continued sauna 3-4x/week • Epsom salt baths 2x/week (magnesium sulfate pulls toxins through skin) • Milk thistle + NAC (liver support) • Taurine, 1-2g (bile flow) • Regular bowel movements (add magnesium/fiber if needed) You need all three steps for successful eradication. Most people try phase 3 while skipping phases 1 and 2. That's like trying to empty a bathtub while the tap is still running. Rules of thumb: • Never outpace our body's ability to clear toxins • If symptoms spike, reduce mobilisation and intensity • Start slow and build up Thanks for reading! Make sure you follow me @bensmithlive for more health protocols in the future.

I spent 4 months cutting my artificial light exposure as much as possible. When I returned to my normal working lifestyle, I realised that blue light blockers don't protecting you from the real damage. They can't fix what's happening at the cellular level, here's how I did:




